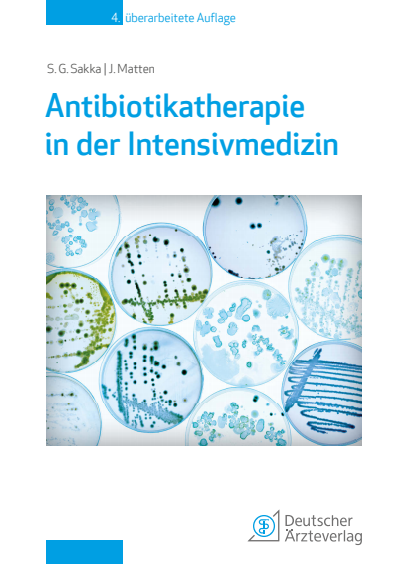
Cover des Buchs: Antibiotikatherapie in der Intensivmedizin

Suchoperatoren helfen Ihnen dabei, Ihre Suchanfragen präziser zu formulieren. Durch die Kombination bestimmter Begriffe und Zeichen können Sie genau festlegen, welche Ergebnisse angezeigt werden sollen.
- +
- bedeutet UND-Operation
- |
- bedeutet ODER-Operation
- -
- negiert ein einzelnes Token
- "
- umschließt eine Reihe von Tokens, um eine Suchphrase zu kennzeichnen
- *
- am Ende eines Begriffs bedeutet eine Präfixabfrage
- (und)
- bedeuten Vorrang